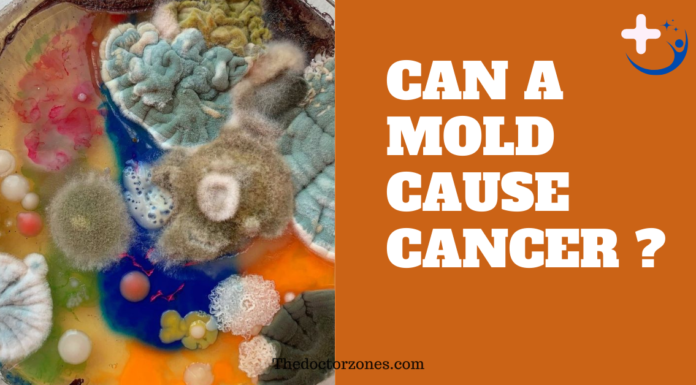
Can Mold Cause Cancer: Separating Fact from Fiction Can Mold Cause Cancer

Is Emphysema Cancer: What causes emphysema
Is Emphysema Cancer
No, emphysema is not a form of cancer. Emphysema is a lung condition characterized by the gradual destruction of the air sacs in the lungs, leading to difficulty breathing and reduced lung function. It is primarily caused by long-term exposure to irritants like cigarette smoke or pollutants. Read more Is Heel Pain...
Breast Cancer Screening ICD 10: Screening for breast cancer ICD 10
Breast Cancer Screening ICD 10
Encounter for screening mammogram for malignant neoplasm of breast. Z12. 31 is a billable/specific ICD-10-CM code that can be used to indicate a diagnosis for reimbursement purposes. Discover about What Level Of Eosinophils Indicate Cancer
https://www.youtube.com/watch?v=-4ZN9IzOQyA
Breast cancer is a significant health concern worldwide, making early detection and screening vital for effective management and treatment. The International...
Is Heel Pain a Sign of Cancer: Heel Pain During Cancer
Is Heel Pain a Sign of Cancer
Heel pain is a common ailment affecting countless individuals across various age groups. Whether you're an athlete or someone with a sedentary lifestyle, experiencing discomfort or pain in the heel can significantly impact your daily activities and quality of life. In this detailed guide, we'll explore the various...
Can A Prolapse Be A Sign Of Cancer
Can A Prolapse Be A Sign Of Cancer?
Yes, a prolapse can sometimes be associated with cancer, but it's important to understand the context and details of the situation. Prolapse refers to the descent or falling down of an organ from its normal position. This can happen in various parts of the body, such as...
What Percentage of Positive Cologuard Tests Are Cancer
What Percentage of Positive Cologuard Tests Are Cancer
Cologuard demonstrates a greater sensitivity in detecting colorectal malignancies compared to the fecal immunochemical test (FIT), with a sensitivity rate of 92% for Cologuard as opposed to 74% for FIT. However, it's worth noting that the false positive rate associated with Cologuard is higher, which means that...
How Does Cancer Man Test You
How Does Cancer Man Test You?
Cancers are water signs, meaning that they're super sensitive and rather emotional. Because of this, he'll want to know if you're capable of treating him with the empathy he needs. He'll pay attention to how you react when someone's emotional and if you support your friends.
Dating a Cancer man...
Can Mold Cause Cancer: Separating Fact from Fiction
Can Mold Cause Cancer
Mold is a type of fungus that thrives in warm, damp, and humid environments, both indoors and outdoors. It reproduces by releasing tiny spores into the air, which can be inhaled by humans. Mold can be found in various places like bathrooms, basements, and even in outdoor environments such as piles...
Is Low Potassium a Sign of Cancer? Yes or NO
Is Low Potassium a Sign of Cancer?
Potassium is a vital mineral that plays a crucial role in maintaining several bodily functions. It helps regulate fluid balance, muscle contractions, and nerve signals. Adequate potassium levels are essential for heart health and overall well-being. When potassium levels drop too low, it can lead to a condition...
What is Kydae Cancer: All You Need to Know
What is Kydae Cancer?
Kydae Cancer is a relatively rare but serious form of cancer that has gained attention in recent years. Understanding this disease is crucial for early detection, effective treatment, and better prognosis. This article delves into the details of Kydae Cancer, covering its causes, symptoms, diagnosis, treatment options, and more.
What is Kydae...
What Level Of Eosinophils Indicate Cancer
What Level Of Eosinophils Indicate Cancer
Eosinophils are a type of white blood cell involved in the immune response, particularly against parasitic infections and allergies. Elevated eosinophil levels, known as eosinophilia, can occur for various reasons, including infections, allergies, autoimmune diseases, and even certain types of cancer. Understanding the role of eosinophils in cancer detection...